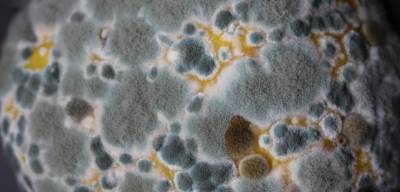

Črevný mikrobióm je mimoriadne dôležitý. Môže ovplyvniť naše celkové zdravie, ale aj náladu. Prečo baktérie žijú v hrubom čreve? A akú úlohu zohrávajú probiotiká v našom celkovom zdraví? Odpoveď sa vám pokúsime poskytnúť v našom dnešnom článku.
Črevná mikroflóra je názov pre živé mikroorganizmy, ktoré s nami žijú v symbióze alebo sa nám snažia škodiť. Ktorá strana zvíťazí, závisí najmä od nás. Hoci je črevný mikrobióm každého človeka jedinečný, jeho stav priamo ovplyvňuje našu stravu a celkový životný štýl. Ten môže ovplyvniť, ktorým baktériám sa v tele darí a ktorým nie. A asi vám nemusíme hovoriť, že takéto premnoženie baktérií v črevách nie je prechádzka ružovou záhradou. (Spomeňte si na svoj posledný záchvat infekčnej hnačky.)
Aby ste ľahšie pochopili úlohu baktérií v našom tele a prečo by sme si mali niektoré z nich vážiť, prinášame vám ich komplexný prehľad.

Funkcie črevných baktérií
Baktérie v črevách sa nevyskytujú len u ľudí. Ale aj u iných zvierat. Vedci sa domnievajú, že ich prítomnosť v našom tele nie je len jednostranne prospešná. (Čo určite neskôr uznáte.) Ak sa na ne pozrieme z čisto funkčného hľadiska, niektoré baktérie dokážu fermentovať nestrávené látky z potravy, ktoré potom môžu byť využité ako zdroj energie. Môžu mať tiež pozitívny vplyv na imunitný systém. Črevná mikroflóra môže regulovať aj rast patogénnych mikroorganizmov.
Baktérie v hrubom čreve
Hrubé črevo je poslednou časťou tráviacej trubice. V hrubom čreve nedochádza k tráveniu potravy, ale k vstrebávaniu živín. (Tlusté črevo je tvorené vodou a anorganickými látkami.) V tejto časti čreva žijú baktérie. Podľa svojich schopností sa delia na fermentatívne a hnilobné.
Čo je vo vnútri, to sa počíta. PROBIOTIKUS sa postará, aby vaše črevá boli plné priateľských baktérií, ktoré podporujú trávenie a posilňujú imunitu. Denná dávka obsahuje 39 miliárd živých kultúr.


Baktérie E. coli v črevách
Zástupcom kvasných baktérií v hrubom čreve je E. coli (alebo Escherichia coli). Kvasinkové baktérie môžu rozkladať celulózu, sacharidy a pektín. V tele sa tak vytvára kyselina mliečna. Vrátane iných látok, ako je alkohol, metán a oxid uhličitý.
Takto vzniknuté kyseliny majú schopnosť znižovať pH črevného obsahu. Je to veľmi dôležité, pretože to zabraňuje hnilobe. Mastné kyseliny, ktoré vznikajú pri činnosti kvasných baktérií, potom slúžia ako energia pre rast nového epitelu. Plyn, ktorý sa tvorí v čreve, je tiež veľmi dôležitý, pretože prispieva k správnej pohyblivosti čreva (každý deň sa v čreve vyprodukuje približne 7-10 litrov plynu, z ktorých sa väčšina reabsorbuje).
Hnilobné baktérie v črevách
Druhým typom baktérií, ktoré žijú v črevách, sú hnilobné baktérie. V tomto prípade hovoríme o baktériách z rodu Proteus. Tieto baktérie môžu z uvoľnených aminokyselín vytvárať ďalšie látky (sírovodík alebo indol). Telo ich potom detoxikuje v pečeni.
Ako prospievajú zdraviu?
Keď už viete, ako funguje tráviaci systém, nie je na škodu dozvedieť sa o vplyve zloženia mikroflóry na ľudské zdravie.
Črevný mikrobióm ovplyvňuje:
- Metabolizmus
- Zápaly
- Niektoré druhy rakoviny (napríklad rakovina hrubého čreva, pri ktorej sa za rizikový faktor považuje kolonizácia určitými škodlivými druhmi)
- Imunitný systém
Z tohto dôvodu by sme sa mali snažiť o čo najčerstvejšiu a najrozmanitejšiu stravu. V strave by nemal chýbať napríklad kefír, ktorý sa považuje za veľmi cenný z hľadiska zdravej mikroflóry. V našom jedálničku by sme mali mať aj dostatok rastlinnej stravy. (Mäso je potrebné, ale je vhodné zvážiť, či je vhodné jesť ho toľko.)



Na črevnú mikroflóru má dobrý vplyv aj pravidelné cvičenie a vyhýbanie sa znečisťujúcim látkam. Hovoríme napríklad o alkohole, rýchlom občerstvení a vysoko spracovaných potravinách. Čo je pre telo dobré, je jednoducho to, čo je najčerstvejšie. (A čo malo najľahšiu cestu na váš tanier.)
Môžete tiež siahnuť po kvalitných doplnkoch stravy, ktoré obsahujú probiotiká. Na dlhodobé užívanie je vhodný probiotický výživový doplnok PROBIOTIKUS. Majte však na pamäti, že pravidelnosť jeho užívania súvisí s premenou vášho životného štýlu. Pretože len tak môžete dosiahnuť optimálne výsledky.
Probiotikus je komplex 11 probiotických kmeňov s prebiotikami, ktoré sa vzájomne podporujú. Denná dávka obsahuje 39 miliárd priateľských baktérií, ktoré pomôžu udržať vaše črevá v rovnováhe.

